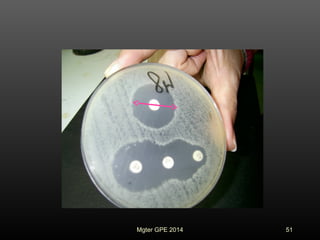
51Mgter GPE 2014

Este documento trata sobre los temas de clasificación de antimicrobianos, mecanismos de acción y resistencia. Cubre la clasificación de antimicrobianos según su estructura química, efecto, espectro de acción y sitio de acción. También describe los mecanismos de resistencia bacteriana como bombas de eflujo, alteración del sitio de acción y enzimática. Finalmente, resume métodos para evaluar la sensibilidad a antimicrobianos como el antibiograma.